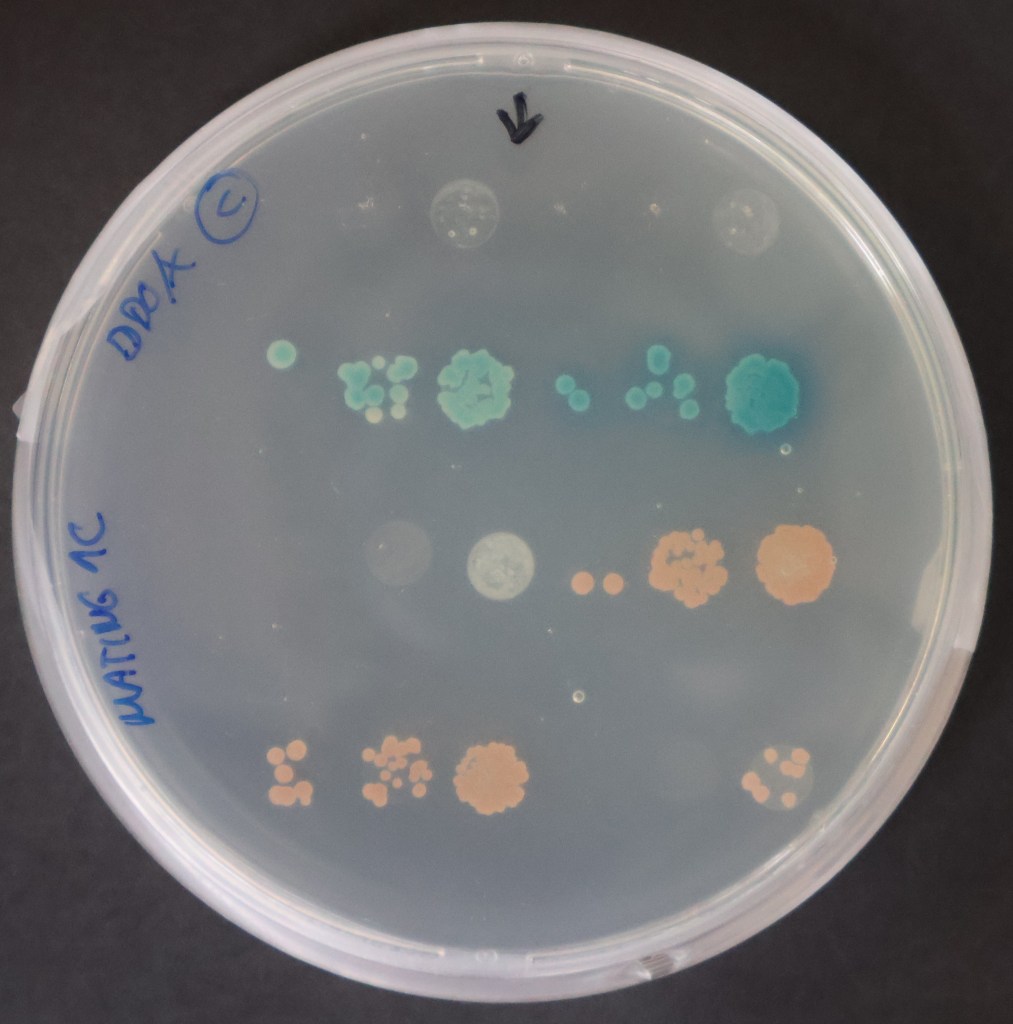

En el IMBL ofertamos contrato (EJ-FASE7-42) de dos 2 años dentro de la convocatoria para la contratación de joven personal investigador y personal técnico de apoyo y de gestión de la I+D+I, en el marco del Programa Fondo Social Europeo. Plus 2021-2027 de Andalucía. https://www.uma.es/servicio-de-investigacion/info/158383/contratacion-de-joven-2026
Si eres Graduada/o en Bioquímica, Biología o Biotecnología y te interesa la Bioquímica y la Biología Molecular de Plantas centrada en la nutrición vegetal este contrato te puede interesar. Entra en la convocatoria para tener más información de las bases y los contratos. SOLICITUDES ABIERTAS hasta el 29 de abril de 2026.